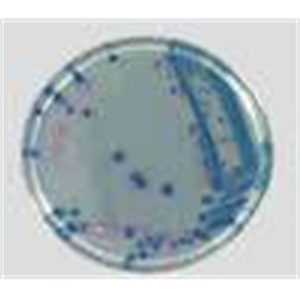
ASH理化制作所 培养基 ESBL

产品分类
- 代理品牌
- 作业工具·自动化控件
- YOKOTA横田
- ATEC艾泰克
- SMC
- SHIBAKEI芝軽粗材
- 韩国KOSAPLUS
- ADVANTECH研华
- UNIPULSE尤尼帕斯
- FUJIKURA藤仓
- TAIYO太阳铁工
- HAHN+KOLB哈恩库博
- 日本AE-MIC
- IRIE入江
- MAKE麦克
- MATSUO松尾电器
- MATSUO松尾电器
- 日本宇科EIKO
- TOSEI东精
- TOSEI东精
- KHK小原齿轮
- OHKURA大仓
- TSUBAKI椿本
- NIPPON GEAR日本齿轮
- MinebeaMitsumi美蓓亚三美
- ENGINEER工程师
- IDEC和泉
- MACOME 码控美
- YASKAWA安川
- TESTO德图
- TAKASAGO高砂
- SHINWA亲和
- SHINKO神港
- SENSEZ 静雄
- OSAKA 大阪牌
- 以色列Ophir
- 仓茂KURAMO
- ISEL艾塞路
- 日本IBS
- CITIZEN西铁城
- KUKEN空研
- SKF 轴承
- 美国PANDUIT泛达
- NSK轴承
- ASCO艾默生
- TAIHEI太平贸易
- tsudakoma津田驹工业
- NACHI不二越
- KABUTO二村
- SUGIYAMA杉山电机
- MUROMOTO室本铁工
- URYU瓜生
- ANRITSU安立计器
- YOKOHAMARIKA横滨理化
- SAKAI酒井
- 日本KTEC
- SK新泻精机
- SHINANO信浓
- TAMAGAWA多摩川
- URAS村上精机
- 日本SR
- KITZMF工业
- KIMO凯茂
- 德国HBM
- ASONE亚速旺
- 德国AKO
- HIKASAGIKEN日笠技研
- MUTOH武腾工业
- rikenkiki 理研机器
- 德国Bansbach
- HORIUCHI堀内
- YAMAHA雅马哈 控制器
- Atos阿托斯
- Wagner 瓦格纳
- M-SYSTEM爱模
- BL 必爱路
- TECLOCK得乐
- 德国Weller
- MASUDA增田
- MACOME玛控美
- HAKKO白光
- ATLAS 阿特拉斯
- ESCO 喜一
- VENN桃太郎
- NITTO KOGYO日东工业
- nittoseiko九州日東
- OKANO冈野
- FEIN 泛音
- MINEBEA美蓓亚
- Autonics奥托尼克斯
- ABB电气
- TAKIKAWA泷川
- KANON中村
- FUJILATEX不二精器
- CSC灯
- KOBOLD科宝
- YAGAMI
- WISE若穂
- SUNAO砂尾
- Schneider施耐德
- OPTEX奥泰斯
- METROL美德龙
- KOSMEK考世美
- 爱发科ULVOIL
- Telemecanique特勒美科
- Nipron尼普龙
- HIOS好握速
- ASAHI旭精工
- KETT凯特
- FUJI IMPULSE富士音派
- CANON ANELVA佳能
- MIDORI绿测器
- KOMYOKK光明理化
- COPAL科宝
- ASADA浅田
- CHELIC气立可
- TOYO东佑达
- TONE 前田
- ORIENTAL MOTOR东方马达
- nihonseiki精器
- lumina扶桑精机
- IZUMI泉精器
- GOEI吴英
- FANUC发那科
- azbil山武
- KAKUTA角田
- KONSEI近藤
- JST工具
- HOZAN 宝山
- KANETEC强力
- VESSEL威威
- UNIPULSE优尼帕斯
- TOHNICHI东日
- SANWA三和
- Minimo
- FUJIELECTRIC富士电机
- AirTAC亚德客
- TOKU东空
- KOGANEI小金井
- HONDA 本多
- CONVUM妙德
- PISCO匹士克
- THK
- PANASONIC松下
- OMRON欧姆龙
- IMAO今尾
- HOKUYO北阳
- FESTO费斯托
- CKD喜开理
- USHIO 牛尾
- TRUSCO 中山
- OKAZAKI冈崎
- B PLUS必安普
- RKC理化工业
- 尼得科Nidec
- SKF
- Parker 派克
- NICHIFU日富
- NBK锅屋
- SENSEZ静雄
- MITSUBOSHI 三星
- KEYENCE
- NOKEN能研
- SUZUKI铃木
- MEPAC MEG
- FREEBEAR福力百亚
- 电子计测·仪器仪表
- AND爱安德
- UEDA植田
- SHOWA-SOKKI昭和测器
- HORIBA堀场
- 美国MEECO
- TIGER光学
- 德国 BRAN LUEBBE
- TELEDYNE分析仪器
- Di-soric德森克
- optris欧普士
- Contrinex科瑞
- ASHCROFT雅斯科
- YAMAMOTO山本计器
- UNITTA优利特
- TOE东京光电子
- ELAYRED 亿莱瑞德气
- 东洋CUSTOM
- ASKER高分子計器
- AIKOH爱光
- Fischer菲希尔
- SHINYEI神荣
- 美国TREK
- 日本TASCO
- EYELA东京理化
- SHARP夏普
- SEKONIC 世光
- 意大利ELITE NDT SA
- CHINO千野
- KANOMAX加野麦克斯
- MARUI KEIKI丸井
- Yamato大和
- HIOKI日置
- ATAGO爱拓
- ONO SOKKI小野测器
- Malcom马康
- WERKA未禾华
- Mitutoyo三丰
- KIKUSUI菊水
- GRAPHTEC图技
- FULUKE 福禄克
- accretech东京精密
- HORIBA堀场
- TORAY东丽
- SK 新泻精机
- VIBRA新光电子
- WATANABE渡边
- IMADA依梦达
- COSMOS新宇宙
- magnescale索尼
- NAGANOKEIKI 长野计器
- KYOWA共和
- 光学设备·特殊光源
- 防静电·耗材
- 管道阀门
- 其他
- KYORITSU共立理化
- 秋月电子通商
- KOMYO光明理化
- KOWA-KASEI兴和化成
- CHUOSEIKI中央精机
- 日本TECNOS特库诺斯
- dinnteco
- 德国PFERD马圈
- 日本Sankei三桂
- TOKI东机产业
- ADVANTECH研华共创
- HONDA本多
- ASK
- EMIC爱美克
- 日本REVOX
- OBISHI大菱计器
- 日本CEJN
- 日本general
- 日本MAXELL
- 日本MTL
- 日本JFM
- 日本GHC
- NABEYA锅屋
- 日本ICOM艾可慕
- JUNKOSHA润工社
- 日本Oiles 奥伊尔斯
- Luceo
- 日本KOENN
- SINFONIA昕芙旎雅科技
- 日本JTEKT
- 日本YUTAKA
- sony索尼
- PURERON
- 日华特陶株式会社
- NICHIRYO立洋
- ASH理化制作所
- 日本MAKE
- ACCRETECH东京精密
- JUST
- KIKUSUI菊水
- NISSIN日伸理化
- ISOLOC
- MICRONORM
- IPF
- STAUBLI史陶比尔
- ALDAK
- METALLUX
- Thermokon
- AUTOSEN
- SHIMURA志村
- NF株式会社
- KSSC产物
- HARMONIC 哈默纳科
- TRANS变压器
- TOYOTAKAKO丰田化工
- SURUGA SEIKI骏河精机
- SUIDEN瑞电
- SAXIN三井化学
- SANKYO富士星
- SANEI三荣电机
- nissei日精
- PELICAN鹈鹕
- PEAK必佳
- NTN恩梯恩
- NIREI仁礼工业
- 日本MYZOX测量
- KYOEI京荣
- 日本KSS
- KONISHI小西
- DIC迪爱生
- ACE GIKEN技研
- KONICA MINOLTA柯尼卡美能
- IEI岩下
- FUDEC藤井
- STD新日電熱
- SEIKO精工
- TOYOZUMI丰澄电机
- SUMITOMO住友
- SIGMA日本西格玛
- ISB井口机工
- EMIC 爱美客
- COSEL科索
- MAEDA KOKI前田机工
- Nihon Keiryoki 计量器工业
- groz beckert格罗茨
- Quixun 显示器
- Yamayu马野化学
- buffalo巴法洛
- NIKON尼康
- Ransburg兰氏
- TOSEI东精
- SIGMA KOKI西格玛
- SANSO三相电机
- NRK理化学
- DKK东亚电波
- YOKOWO友华
- KOKUYO国誉
- LUBE泵
- NICHIGI日油技研
- TOCOS 炭素抵抗器
- AIRTECH安泰
- SEKISUI积水
- SAKAGUCHI坂口电热
- Maruyama 丸山
- LECIP三阳
- IWAKI易威奇
- HITACHI日立
- DAIION电机
- OGURA CLUTCH小仓
- TOGI东洋技研
- TOZEN滔辰
- SAKURA 樱花
- JRM 电子
- JEOL电子
- AichiTokei 爱知时计
- MITSUBISHI 三菱
- FUJIFILM富士
- KLUEBER克鲁勃
- FUKUDA福田电机